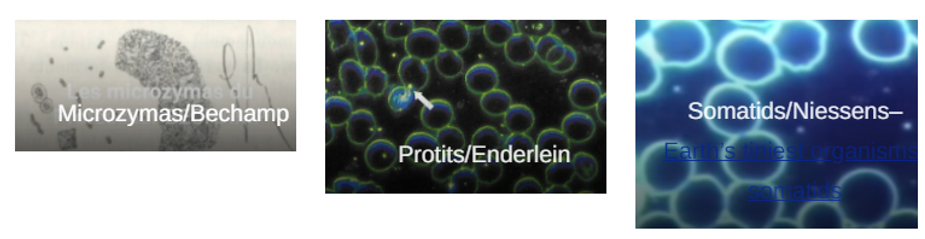

Greater Cause of Disease Are Not From Germs but From The Terrain Within!
Updated: Jan 10, 2023

The Documentar Film: https://checkout.terrainthefilm.com/offers/krVXPVkG/checkout
The Hidden Science: Greater Cause of Disease Not Germs but Terrain | From Pleomorphism of Microzymas – Educative Panel on Terrain with Dr. Robert Young and Dr. Andy Kaufman

In Report 279: Panel on Terrain recorded last Friday, January 28, now published at Bitchute, Brighteon, Odysee, and Rumble (video links below), Dr. Robert Young and Dr. Andy Kaufman discussed their discoveries of 19th century French scientist Antoine Bechamp’s (1816 – 1908) groundbreaking Terrain Theory after he examined cells at the molecular level and found that disease and ill-health stem primarily from unhealthy and acidic internal environments, as also did French physician and physiologist Claude Bernard (1813 -1878) with his focus on the “milieu interieur”– a change from the narratives of Germ Theory which tell us infectious disease comes to us primarily from the outside, on the backs of microscopic bat viruses, fleas, lice, ticks, et al.

“The stability of the internal environment [the milieu intérieur] is the condition for the free and independent life.”– Claude Bernard

Hidden Science We Don’t Hear About from the CDC, WHO NIAID, or Departments of Health

Under the microscope, Dr. Young reveals, Bechamp uncovered specks of granular life beyond cellular, nuclear, and DNA structures he termed microzymas and posited to exist in all human, plant, and animal life, atoms of indestructible life which would never perish but transform into microorganisms on the death of the host organism–later or seemingly coincidentally named protits by Gunther Enderlein, and similar in concept, says Dr. Andy Kaufman, to the somatids of Gaston Naessen, bions of Wilhelm Reich, and to embryonic stem cells, which have the capacity to develop into other cells like heart cells and brain cells.

Dr. Robert Young relates that scientists after Bechamp like Professor Gunther Enderlein (1872 – 1968), an entomologist, physician, and live-blood microscopist, and his protege Professor Med. Dr. Marie Bleker, the latter whom he closely studied with in Germany, found that these microzymas have the capacity to form life into healthy cells in healthy alkaline environments or form into bacteria, yeast and mold of different kinds in acidic environments.

Another scientist and Enderlein student, Dr. Young informs us, is Dr. Virginia Livingston-Wheeler who has theorized an endogenous microscopic living form she named Progenitor Cryptocides as cause for cancer in the body–a form which undergoes pleomorphism into a yeast-like form in a diseased environment but remains dormant otherwise.


Dr. Young has published several videos at his channel showing this astonishing conversion of a red blood cell to anthrax rod bacillus and back again, and says that his independent discovery of this phenomenon under the microscope when examining the blood in 1994 of a young woman with insulin-dependent Diabetes Mellitus led only later to his learning of Antoine Bechamp in 1996.
Excerpt from Dr. Young’s video, The Biological Transformation of a Red Blood Cell to Anthrax Bacteria



Traveling to Paris in the late ’90s to find out more and read Bechamp’s not-readily available work, Dr. Young reports he was inspired and deeply moved by his finding of microfiches of Bechamp’s hand-drawn microzymas in his books Les Microzymas and Les Microzymas et Microbes in the University of Paris library, which confirmed and validated his own discoveries of pleomorphing red blood cells.

In an extension, although left unrecognized, of Bechamp’s original discoveries of microzymas being the building blocks of all life, Professor Gunther Enderlein studied what Antoine Bechamp studied, and also found pulsing points of life in live blood he termed “protits,” positing eventually that bacterial forms can arise from these, and are not “monomorphic” as Louis Pasteur expressed, having a single, discrete form, but pleomorphic in nature, having the ability to change forms in a cycle of creation.

Bacterial forms in fact, they found, form primarily to try to clean up the acids and toxins in unhealthy acidic plasma, and can be returned to the shape of healthy cells after toxic-waste-clean-up in the right alkaline environment, in an extraordinary and fascinating process heretofore hidden from larger awareness by the Germologists of Modern Pharmaceutically-Shaped Science:
Pleomorphism.

Larger Implications for a New Understanding of Health
This suggests that germs are endogenous and rise from inside us — and are not lone micro-organisms existing outside, waiting to opportunistically invade and exploit our well-being in waves of infection, contagion, pandemic or endemic, as Virologists and Germologists would have it.


Instead, all health and disease is determined by our own actions, thoughts, and attitudes–our lack of nutrition, exercise, rest and restoration, relaxation and so on, and the toxic stresses on us–chemical, radiation/EMF, environmental, physical, each producing specific bio-effects, which give rise, Dr. Young says, to unhealthy acidic environments inside us, plunging the pH of our interstitial fluids (fluid between cells), vascular fluids (fluid inside blood vessels), and cellular fluids (fluid inside cells) to dangerous and toxified levels much lower than the optimal baseline levels that they and we need to be in good health and thrive.

https://staging.drrobertyoung.com/post/get-off-your-acid

A truly revolutionary concept with the capacity to overturn all conventional and militarized concepts of our bodies as battlefields and germs as hostile warriors, pleomorphism offers a magical lens to view the fluid transformation and totality of all life. In Antoine Bechamp’s words, “Nothing created is lost. Nothing becomes a prey to death, everything becomes a prey to life.”

In addition Dr. Kaufman addresses in close focus the faulty concept of Virus-Isolation on which germologists predicate Virus-Replication, proof for either of which really does not exist, given that what they begin with and call “isolation” is in actuality NOT isolation–unable to produce a finite specific form from the debris of patient sputum or patient specimen which they admittedly mix with Vero cells–diseased African monkey kidney cells, as well as fetal cells, bovine calf serum, formaldehyde, antibiotics and other chemicals and toxins, they arbitrarily fixate on shreds of debris containing immiscible genetic matter–bits of RNA encased in bits of cellular membrane–extruded from cells, and call these “viruses” which they then genetically sequence using amplification processes like the faulty PCR.

In no way shape or form, scientifically, logically, reasonably or otherwise can they say they have extracted a specific virus from patient sputum after subjecting it to this mix-up-and-stir miasma-creation process, Dr. Kaufman explains, and which leads only, Dr. Young says, to a “Frankensteinian concoction filled with random anatomical elements.”
Are Virologists Looking for a Jaguar in a Forest of Pumas?
No proof of replication of virus exists either, Dr. Kaufman notes, even though many molecular biologists and microbiologists will swear to seeing a “proliferation, replication, or reproduction” of their said-to-be-isolated virus in test-tubes, cell-cultures and petri dishes.
What exactly are they looking at then is the question, if no virus can truly be isolated in a finite, visible, discrete and preservable form?
What are they looking for, notes Dr. Kaufman, may be the more apt question; using a provocative analogy of wild cats in a jungle, he notes that setting out to find a jaguar without knowing what it looks like may lead to hunters rushing after spotted leopards or pumas “or any other feline” and calling it a jaguar. In other words, scientists who tell us they can see viruses replicating cannot prove and have not proved what is replicating.

Living Blood and Living Bodies
In past presentations, both Dr. Kaufman and Dr. Young have discussed the possibility of what is known to be exosomes extruded from cells in the presence of toxins being mistaken for viruses. An important fact to note, say both doctors, is that virus-isolation in labs occurs only in dead cells and tissue and not in living cells; the work that Antoine Bechamp, Dr. Enderlein, and Dr. Young have all done, making discoveries in dark field or phase contrast microscopy under the compound optical microscope, has been with live blood and living fluids.


The route to health, Dr. Young reiterates is to maintain a healthy alkaline balance in the fluids of the body with healthy nutrition and lifestyle choices. Influenced by his studies with Marie Bleker, and evolving from his own inquiries into health through live and dried blood microscopy, Dr. Young has coined the term The “New Biology” to describe his approach to health.



In tracing his influences and personal discoveries of Bechamp and Terrain theory, Dr. Kaufman names the work of Kelly Brogan, in introducing nutrition and herbal remedies to the treatment of psychiatric ailments such as depression, success with which led him onward in search of the true keys to health, physical and mental, coinciding with the launch of the questionable “plandemic” which also led to his deeper inquiries into virus isolation, for which he has now become well-known, and which he has spoken of in previous podcasts at my channel as elsewhere.
Authentic Medicine marks the name of his ventures in holistic healing, and he too stresses that the human body is filled with natural wisdom and a great intrinsic power for self-healing.

What Do Vaccines and Rattlesnakes Have in Common? They Both Contain a Deadly Poison or Venom and if Injected Will Cause Serious Injury or Death!
Meanwhile the injecting of venomous poisons for the purpose of provoking the creation of so-called antibodies which is what vaccination are purported to do, can be likened to a snake bite, says Dr. Andy Kaufman, injecting dangerous life-threatening venom into the body, a “perfect analogy” Dr. Young says he has also used: the very opposite of health creation.

A rather brilliant meme (source unknown) tying vaccines to chem trails and HAARP’s phased-array antennas via Snake Bite Majeure–a not so far-fetched depiction in light of the new discoveries in COVID vaccines of nanographene biosensors and circuits intended for Mad-Scientist 5G and Terahertz dialing-up of human bodies and brains via COVID vaccines to the Internet of Things, Internet of Nano Bio Things, Internet of Bodies, and Internet of Interlinked Ailing Technocrat Brains Hungry for Yours!
Reminding us that he has examined the Pfizer COVID vaccines under the microscope as also vaccinated blood, reported here earlier in a few articles including this one, Dr. Young refers back to the poisoning of the body with acidifying toxins which put a greater burden on the natural health-orienting, self-healing mechanisms of the human body.

A wide-ranging and detailed presentation from both doctors, this panel on Terrain offers a turning-point in the public understanding of health and disease, which have both been hijacked so far by the virologists and vaccine-makers propping up a diseased profit-driven paradigm run by Big Harma, and which has, through the aegis of politically-minded and totalitarianism-intending over-reachers and abusers of power at the WHO, WEF, and world governments kowtowing to them, ground to a halt currently clutching its unacceptable and absurd valise of Forever lasting Pandemic (reported here earlier).
Who is Robert O. Young CPC, DSc, PhD and Naturopathic Practitioner (to view CV & Recent Publicatons click here)

The following is a portion of my work that was published 22 years later as a declaration for those who have eyes to see and hears to hear the mysteries of the Creator!

Click on the above picture or on this link to order your personally signed copy of “The Finger on the Magic of Life”. Please read, learn and share this article with everyone who you love and care about so they can be at peace within and know there is “nothing to fear but fear itself.” Franklin D. Roosevelt 1933 Citation: Young RO (2016) Who Had Their Finger on the Magic of Life – Antoine Bechamp or Louis Pasteur?. Int J Vaccines Vaccin 2(5): 00047. DOI: 10.15406/ijvv.2016.02.00047

Citation: Young RO (2016) Second Thoughts about Viruses, Vaccines, and the HIV/AIDS Hypothesis – Part 1. Int J Vaccines Vaccin 2(3): 00032. DOI: 10.15406/ijvv.2016.02.00032

Click on this link for my published paper on the truth about Polio and Measles: https://www.amazon.com/POSSIBLE-POST-POLIO-LEGIONNAIRES-CANCER-EPIDEMIC-ebook/dp/B01MAZ0G39 biological transformation was recorded in 1994 by Dr. Robert O Young! The truth often comes out when the angel of death is standing at YOUR doorstep. Now is the time to prepare to live your life with health, energy, passion and integrity. You must be the change and the cure you want to see.
To learn more about the research of Robert O. Young go to: https://staging.drrobertyoung.com/blog and watch the following interview with Ramola D, Dr. Robert O. Young

https://www.bitchute.com/video/ufDTR2WopE5p/
NEWSBREAK 142 | BREAKING: DR. YOUNG REVEALS COVID VACCINES ARE INTELLIGENT TARGETING BIOWEAPONS Ep. 261: Dr. Robert O. Young on Terrain Theory: Unorthodox Thoughts on How to Be Healthy (Part I)

https://greensmoothiegirl.com/your-high-vibration-life/episodes/terrain-theory-dr-robert-o-young-part-1/ Dr. Robert Young has devoted his career to discovering the ‘missing pieces” within the larger picture of health. With a specialty in cellular nutrition, biochemistry, and microbiology, his entire career has been focused on health at the cellular level, researching the true causes of “disease” and cellular repair. Dr. Young is the author of more than 100 peer-reviewed articles published in several noted journals, including The Journal of Alternative and Complementary Medicine. He is the author and co-author of many books, including the pH Miracle for Cancer and most recently The Cancer Solution, published in 2018. The pH Miracle series of books has sold over 10 million copies, has been translated into 29 languages and has gained a widespread following in more than 159 countries. You will want to listen to this interview several times – and share with everyone you know. Dr. Young explains: > how to remove graphene oxide from your body > how to protect yourself from radiation/EMF frequencies > how to heal from almost every symptom you have….for pennies a day > why the most important part of your immune system is NOT your white blood cells >… and so much more in this hour presentation PACKED with important information – Website: https://staging.drrobertyoung.com/post/the-prevention-cure-for-cancer
Blog: www.drrobertyoung/.blog
A few articles: Alkalizing Nutritional Therapy in the Prevention and Treatment of Any Cancerous Condition – The International Journal of Complementary and Alternative Medicine

https://www.phmiracleproducts.com/collections/books-audio-video/products/alkalizing-nutritional-therapy



LINKS FOR Dr. ANDY KAUFMAN: Website: https://andrewkaufmanmd.com/
COVID-19 Myths Webinar series: https://andrewkaufmanmd.com/live-webinars/
STATEMENT ON VIRUS ISOLATION: https://andrewkaufmanmd.com/sovi/
RECENT PODCAST WITH DR. ANDY KAUFMAN: Report 259: Dr. Andy Kaufman and Dr. Amandha Vollmer Expose COVID Vaccine Fraud & Science Deception https://www.bitchute.com/video/8kVLIr5rqkeE/

RAMOLA D REPORTS: Support at Patreon: Patreon.com/RamolaD or Paypal: Paypal.me/RamolaD
FIND PRINT/VIDEO CONTENT: Media Site and Magazine: everydayconcerned.net
Leave a comment Posted in COVID-19, Halt the Vaccines, Health, Health and Healing, Public Health, Vaccine Truth, Vaccines, Waking Up Tagged Antoine Bechamp, bions, Claude Bernard, Dr. Andy Kaufman, Dr. Gaston Niessens, Dr. Gunther Enderlein, Dr. Marie Bleker, Dr. Robert Young, Dr. Virginia Livingstone-Wheeler, greater cause of disease, hidden science, Kelly Brogan, microzymas, Panel on Terrain, pleomorphism, protits, Ramola D Reports, Report 279, somatids, terrain not germs, Terrain theory, Wilhelm Reich



